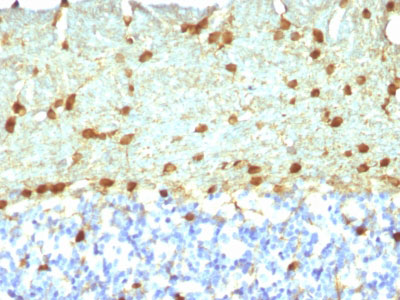

> Antigen, Antibodies, ELISA, Western Blot > Primary Antibody > Monoclonal Antibodies > Fascin-1 (Reed-Sternberg Cell Marker) Antibody - Without BSA and AzideBrand |
Leading Biology | Catalog Number |
APR14645G |
Product Type |
Monoclonal Antibodies | Field of Research |
|
Product Overview |
We constantly strive to ensure we provide our customers with the best antibodies. As a result of this work we offer this antibody in purified format.
We are in the process of updating our datasheets. If you have any questions regarding this update, please feel free to contact our technical support team.
This product is a high quality Fascin-1 (Reed-Sternberg Cell Marker) antibody - Without BSA and Azide.
|
||
Molecular Weight |
55kDa
|
||
Cellular Localization |
Antigen Cellular Localization:
Cytoplasm, cytoskeleton. Cell projection, filopodium. Cell projection, invadopodium. Cytoplasm, cytosol Note=In glioma cells, partially colocalizes with F-actin stress fibers in the cytosol
|
||
Host |
Mouse
|
||
Species Reactivity |
Human, Rat
|
||
Clone |
FSCN1/418
|
||
Isotype |
Mouse / IgG2b, kappa
|
||
Symbol |
FAN1, HSN, SNL
|
||
GeneID |
|||
UniProt ID |
|||
Function |
Organizes filamentous actin into bundles with a minimum of 4.1:1 actin/fascin ratio. Plays a role in the organization of actin filament bundles and the formation of microspikes, membrane ruffles, and stress fibers. Important for the formation of a diverse set of cell protrusions, such as filopodia, and for cell motility and migration.
|
||
Summary |
Recognizes a protein of 55kDa, which is identified as fascin-1. Its actin binding ability is regulated by phosphorylation. Antibody to fascin-1 is a very sensitive marker for Reed-Sternberg cells and variants in nodular sclerosis, mixed cellularity, and lymphocyte depletion Hodgkin s disease. It is uniformly negative in lymphoid cells, plasma cells, and myeloid cells. Fascin-1 is also expressed in dendritic cells. This marker may be helpful to distinguish between Hodgkin lymphoma and non-Hodgkin lymphoma in difficult cases. Also, the lack of expression of fascin-1 in the neoplastic follicles in follicular lymphoma may be helpful in distinguishing these lymphomas from reactive follicular hyperplasia in which the number of follicular dendritic cells is normal or increased. Antibody to fascin-1 has been suggested as a prognostic marker in neuroendocrine neoplasms of the lung as well as in ovarian cancer. Fascin-1 expression may be induced by Epstein-Barr virus (EBV) infection of B cells with the possibility that viral induction of fascin in lymphoid or other cell types must also be considered in EBV-positive cases.
|
||
Form |
Liquid |
||
Storage & Stability |
Store at +4°C short term. For long-term storage, aliquot and store at -20°C or below. Stable for 12 months at -20°C. Avoid repeated freeze-thaw cycles.
|
||
Applications |
IHC-P, IF, FC
|
||
Synonyms |
Fascin, 55 kDa actin-bundling protein, Singed-like protein, p55, FSCN1, FAN1, HSN, SNL
|
||
Images |

Formalin-fixed, paraffin-embedded human Hodgkin's Lymphoma stained with Fascin-1 Monoclonal Antibody (FSCN1/418)
Formalin-fixed, paraffin-embedded Rat Brain stained with Fascin-1 Monoclonal Antibody (FSCN1/418) |
||
Specification |
|||
Quantity |
|
||
| Select | Brand | Catalog No. | Product Name | Pack Size | Type | Field of Research | Specification | Quantity | Price(USD) | |
| 1 | Leading Biology | APG02467G | CCK4 / PTK7 Antibody (clone 4F9) | 50 μl | Monoclonal Antibodies |
|
$495.00 | Add Ask | ||
| 2 | Leading Biology | AMM04683G | GALT Antibody (clone 4C11) | 50 μg | Monoclonal Antibodies |
|
$545.00 | Add Ask | ||
| 3 | Leading Biology | AMM01402G | Vimentin (Mesenchymal Cell Marker) Antibody - With BSA and Azide | 50 ug | Monoclonal Antibodies |
|
$395.00 | Add Ask | ||
| 4 | Leading Biology | APR08280G | LTA4H / LTA4 Antibody (clone 9G8) | 50 μl | Monoclonal Antibodies |
|
$495.00 | Add Ask | ||
| 5 | Leading Biology | AMM00172G | CD1a / HTA1 (Mature Langerhans Cells Marker) Antibody - With BSA and Azide | 50 ug | Monoclonal Antibodies |
|
$395.00 | Add Ask | ||
| 6 | Leading Biology | AMM05750G | CEBPA Antibody | 100 μl | Monoclonal Antibodies |
|
$545.00 | Add Ask |
 Leading Biology Inc.
2600 Hilltop DR, Building G, B Suite C138
Richmond, CA, 94806
Tel: 1-661-524(LBI)-0262
Email: info@leadingbiology.com
Leading Biology Inc.
2600 Hilltop DR, Building G, B Suite C138
Richmond, CA, 94806
Tel: 1-661-524(LBI)-0262
Email: info@leadingbiology.com
Complete this form and click send to ask us a question, request a quote or simply say hello.

You have 0 item in your cart

You have 0 item in your inquiry list
